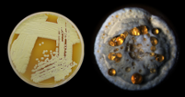

Nieuwe antibiotica
Ziekteverwekkende bacteriën zijn steeds vaker resistent voor de huidige antibiotica. De vraag naar nieuwe antibiotica wordt daarmee steeds groter. Professor Gilles van Wezel zoekt naar nieuwe vormen van antibiotica in goede bacteriën die in de grond leven.
Slapende genen
Veel van de huidige antibiotica worden gemaakt door een speciaal soort grondbacteriën, de streptomyceten. Deze grondbacteriën produceren antibiotica om andere (schadelijke) bacteriën uit de buurt te houden. Tientallen jaren werd gedacht dat een zeer intensief bestudeerd type streptomyceet, de Streptomyces coelicolor, hooguit vier verschillende antibiotica kon produceren. Het blijkt echter dat deze en andere streptomyceten groepjes antibiotica producerende genen bevatten die nog niet eerder waren gezien. Blijkbaar zijn de meeste van deze genen 'in slaap' onder laboratoriumcondities.
Moleculaire schakelaars
Professor Gilles van Wezel, hoogleraar moleculaire biotechnologie, zoekt samen met zijn collega's naar moleculen die kunnen dienen als schakelaar om deze slapende genen tot leven te wekken en zo nieuwe soorten antibiotica te produceren. Onderzoekers screenen bijvoorbeeld bibliotheken van chemische stoffen in de hoop dat daar geschikte moleculen tussen zitten om deze genen te activeren.
Leren van de natuur
Daarnaast zoekt Van Wezel ook gericht naar moleculaire schakelaars in de natuur. Hij verklaart: 'Je mag ervan uitgaan dat er omstandigheden zijn in de grond die de bacterie ertoe aanzetten om deze slapende antibiotica te produceren. Anders zouden deze genen niet zo lang zijn behouden gedurende evolutie.' Inderdaad ontdekte hij, samen met onderzoekers uit Leiden en Wageningen, dat planten een verbinding produceren die streptomyceten aanzet tot antibioticaproductie wanneer er een andere, schadelijke bacterie in de buurt van de plant komt. Het molecuul dat de plant produceert is dus zo'n moleculaire schakelaar. De toepassing ervan wordt nu verder onderzocht.
Breed inzetbare technologie
Het bestuderen van natuurlijke processen bij streptomyceten heeft al een aantal zeer veelbelovende nieuwe verbindingen opgeleverd voor nieuwe antibiotica. De techniek is volgens Van Wezel nog veel breder inzetbaar: 'Streptomyceten produceren allerlei verbindingen om zich te verweren tegen hogere organismen zoals schimmels en wormen. Die kunnen de basis vormen voor allerlei soorten medicijnen. Verschillende anti-tumormiddelen zijn bijvoorbeeld ook uit streptomyceten afkomstig. Ik denk dat je via deze weg veel meer kans hebt op totaal nieuwe stoffen dan wanneer je uitgaat van een screening van een algemene bibliotheek van chemische stoffen. Deze aanpak werkt.'
